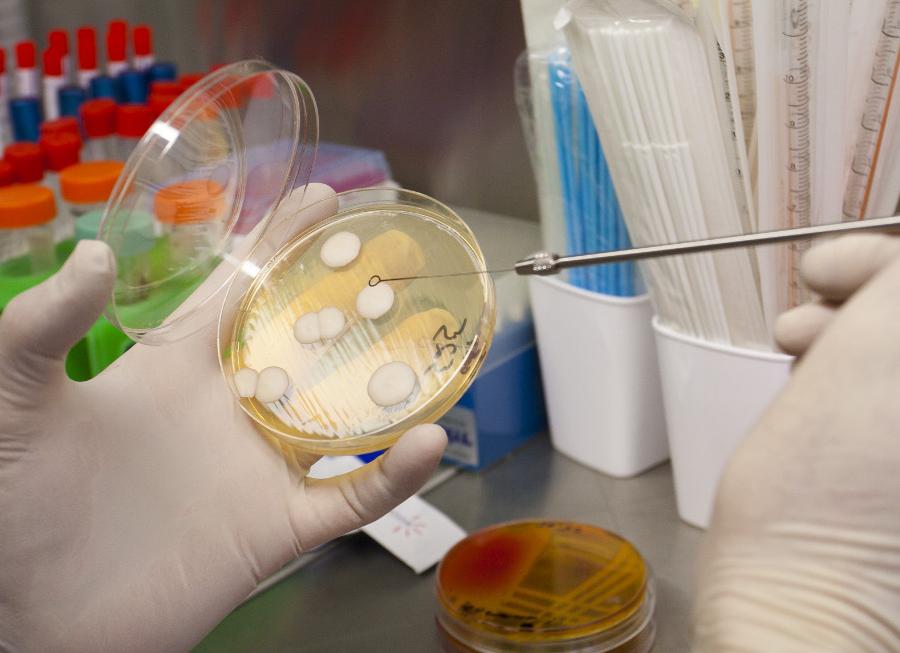
Бак посев это что такое

Бак посев это что такое
[Бак посев это что такое]
[Бак посев это что такое]
Бак посев мазка что это такое
Что такое бакпосев и зачем он нужен
Зачем нужен бакпосев
Данный метод исследования производится путем посева биологического материала человека на определенные питательные среды, которые создают в лаборатории. Через определенное количество времени биоматериал «обрастает» микроорганизмами, в последствии их тестируют на чувствительность к противомикробным средствам и антибиотикам. По результатам анализа составляется антибиотикограмма, которая показывает, от какого препарата быстрее всего погибает возбудитель. Эта информация используется для назначения лечения. Бак посев на микрофлору широко применяется для выявления причины различных инфекций и воспалений. Он помогает идентифицировать возбудителя и подобрать наиболее эффективное лекарство. Концентрация микроорганизмов в биоматериале измеряется в КОЕ/мл (колониеобразующих единицах).







